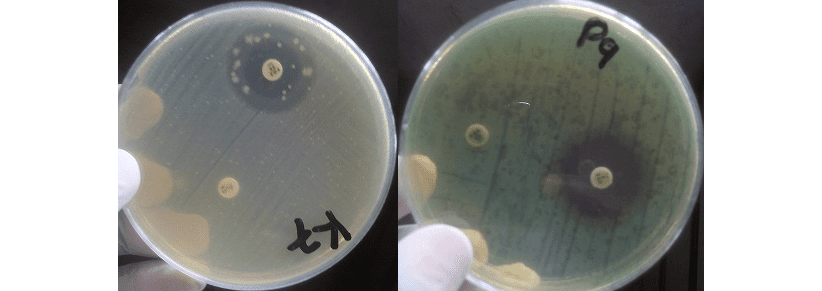
AmpC ENZYMES

Western blotting, also known as protein immunoblotting, is a widely used analytical technique in molecular […]
Author: Dr. Chika Ejikeugwu
Northern Blotting Technique: Principles, Methodology, and Applications in RNA Detection
Northern blotting is a classical molecular biology technique used to detect and analyze specific sequences […]
Herpesviridae Family: Structure, Replication, and Disease Burden of Herpesviruses
The family Herpesviridae comprises a large and diverse group of enveloped double-stranded DNA viruses that infect a […]
Adenoviridae Family: Structure, Diversity, Pathogenesis, and Economic Significance
Adenoviridae family comprises a diverse group of non-enveloped, double-stranded DNA viruses that infect a wide range […]
Southern Blotting Technique: Principles, Methodology, and Applications in Molecular Biology
Southern blotting, developed by Sir Edward M. Southern in 1975, is a molecular technique used to detect specific DNA sequences. It involves transferring DNA from a gel to a nitrocellulose membrane, followed by hybridization with radiolabeled probes. This method is pivotal in DNA analysis, forensic science, and paternity testing.
Hepadnaviridae Family and Human Hepatitis B Virus (HBV): Structure, Biology, Pathogenesis, and Preventive Strategies
The family Hepadnaviridae comprises a distinctive group of small hepatotropic DNA viruses that primarily infect the liver […]
RNA Viruses: Structure, Genome Characteristics, and Intracellular Replication
RNA viruses constitute a major class of infectious agents whose genomes are composed of ribonucleic […]
Blotting Technique: Understanding and Applying Blotting Techniques for Molecular Analysis
Blotting is used in molecular biology to transfer nucleic acids and proteins from gel to a membrane for identification and analysis. Developed in the 1970s, it combines electrophoresis and immunological methods. There are three main types: Southern (DNA), Northern (RNA), and Western (proteins), each allowing detection and measurement of specific molecules.
Polyomaviridae family: Structure, Replication, Pathogenesis, Treatment and Control
The family Polyomaviridae comprises a group of small, non-enveloped DNA viruses capable of infecting a wide range […]
Ethidium Bromide Staining in Gel Electrophoresis
Ethidium bromide (EtBr) is a fluorescent intercalating agent widely used in molecular biology to visualize […]
Other β-Lactam and Non-β-Lactam Antibiotics Targeting Bacterial Cell Wall Synthesis
Aside from penicillins and cephalosporins, several other β-lactam and non-β-lactam antibiotics have been developed and […]
Papillomaviridae Family: Biology, Structure, Pathogenic Mechanisms and Human Disease
The Papillomaviridae family comprises a large and diverse group of small, non-enveloped DNA viruses collectively referred to […]
Confocal Microscopy: Understanding Principles, Instrumentation, and Applications of Confocal Microscope
Confocal microscopy is defined as an optical imaging technique that enhances optical resolution and contrast […]
Biowarfare: Epidemiology, Detection, Control, Prevention, and Global Public Health Implications
Biological and chemical weapons, while unlikely to be used in conventional warfare, represent an ongoing […]
Poxviridae: Classification, Replication, and Clinical Significance
The Poxviridae family represents one of the most biologically distinctive groups of DNA viruses known to infect […]
Nanoscale Secondary Ion Mass Spectrometry (NanoSIMS)
NanoSIMS is the acronym for Nanoscale Secondary Ion Mass Spectrometry. NanoSIMS is a high-resolution analytical technique […]
Parvoviridae Family: Structure, Replication, Clinical Significance, and Human Disease
The Parvoviridae family comprises a group of very small DNA viruses that infect both humans and animals. […]
Understanding the Major Transmission Routes of Biological and Chemical Agents
Biological and chemical agents used in bioterrorism can be transmitted to human or animal populations […]
Fluorescence microscopy
Fluorescence microscopy is an advanced optical imaging technique that utilizes the phenomenon of fluorescence to […]
Overview of other Hazardous Chemicals used as Agents of Chemical Warfare: Mechanisms, Effects, and Implications for Human Health
Chemical warfare agents represent a diverse set of toxic compounds designed to harm or incapacitate […]
Understanding Hantavirus Infection: Transmission, Symptoms, and Prevention
Hantaviruses are classified as Category C biological agents, the third-highest priority group of pathogens considered to […]
Raman Microscopy: How Raman Microscopy is Transforming Microbial Analysis
Raman microscopy is an advanced analytical technique that integrates Raman spectroscopy with optical microscopy to enable spatially resolved […]
Category C Biological Agents – Emerging Threats in Public Health: Understanding Category “C” Biological Agents and Their Potential for Future Bioterrorism
Category “C” biological agents occupy a distinct and critical niche in the spectrum of emerging […]
Category B Biological Agents: microbiology, transmission pathways, clinical manifestations
Category B biological agents constitute the second highest priority group of biological threat agents in public health […]
Category A Biological Agents: How to Identify, Contain, and Prepare for the Highest-Risk Biothreats
Category A biological agents are pathogens or toxins classified by the Centers for Disease Control and […]
Microbes Used as Biological Weapons: Bioterrorism Threats and Global Biosecurity Measures
Microorganisms have long been recognized not only for their role in disease and ecology but […]
BIOTERRORISM: Definition & Attributes of Biological Agents used for Biowarfare
Bioterrorism is broadly defined as the unauthorized, deliberate, or threatened use of microorganisms including bacteria, […]
Microbiological Risk Assessment: Identification, Evaluation, and Control of Biological Hazards
Microbiological risk assessment (MRA) is a systematic and structured process used to evaluate the potential […]
Bioterrorism Through History: From Ancient Biological Warfare to Modern Global Security Threats
Bioterrorism refers to the deliberate use of biological agents such as bacteria, viruses, fungi, or […]
MUSHROOM FARMING: Improving Yield and Productivity in Mushroom Farming Systems
Mushrooms are macroscopic fungi that produce visible fruiting bodies, commonly characterized by an umbrella-like structure. […]
Eutrophication Management: Causes, Impacts, and Practical Strategies to Prevent Algal Blooms
Eutrophication refers to the enrichment of aquatic ecosystems with excessive amounts of inorganic nutrients, primarily nitrogen […]
Bioremediation: An Actionable, Cost-Effective Strategy for Restoring Contaminated Soil and Water
Bioremediation is a scientifically grounded, sustainable approach to environmental clean-up that harnesses biological systems to […]
Composting: Harnessing Composting to Transform Organic Waste into Sustainable Soil Fertility and Environmental Resilience
Composting is one of the most practical, sustainable, and environmentally sound approaches for managing organic […]
Sulphur cycle: Managing the Sulphur Cycle for Ecosystem Productivity, Environmental Quality, and Sustainable Development
The sulphur cycle is a fundamental biogeochemical cycle that regulates the movement, transformation, and availability […]
Oxygen cycle: Understanding and Sustaining the Oxygen Cycle, its Processes, Functions, and Implications for Life on Earth
The oxygen cycle is one of the most fundamental biogeochemical cycles on Earth, underpinning the […]
Phosphorus cycle: Managing the Phosphorus Cycle for Sustainable Ecosystems and Food Security
The phosphorus cycle is a fundamental biogeochemical process that governs the movement and transformation of […]
Nitrogen cycle: Understanding and Managing the Nitrogen Cycle for Ecosystem Sustainability
The nitrogen cycle is a fundamental biogeochemical process through which nitrogen is exchanged between the […]
Carbon cycle: Enhancing Understanding and Stewardship of the Carbon Cycle for a Sustainable Planet
Carbon is the fundamental element that anchors all organic compounds in the ecosystem. It serves […]
Biogeochemical Cycles and Their Importance to Life on Earth
The term biogeochemical is derived from the combination of three distinct but interrelated words: bio, geo, and chemical. The prefix bio refers […]
Digital PCR (dPCR): The Next Frontier in Absolute Nucleic Acid Quantification
Digital PCR (dPCR) is a method of quantifying nucleic acid (DNA or RNA) targets without […]
From Genes to Joints: Understanding Rheumatoid Arthritis as an Autoimmune Disease
Autoimmune diseases occur when the body’s immune system mistakenly attacks its own healthy cells and tissues, […]
Schistosomiasis and One Health: Tackling a Snail-Borne Threat to Humans, Animals, and Ecosystems
Schistosomiasis, also known as bilharzia, is a debilitating water-borne disease caused by parasitic blood flukes […]
From Soil to Solution: How Streptomycin is Extracted and Evaluated
Antibiotics remain one of the most important discoveries in medical science, serving as a cornerstone […]
How Global Change Contributes to the Spread of Infectious Diseases
The dynamics of infectious disease transmission are shaped by a complex interplay of environmental, biological, […]
From Mosquito Bite to Global Threat: Is Chikungunya the Next Pandemic?
Chikungunya (CHIKV) is a mosquito-borne viral disease marked by sudden onset fever and severe joint […]
Metaproteomics & Transcriptomics
What is Metaproteomics? Metaproteomics refers to the large-scale characterization of the complete set of proteins […]
AmpC ENZYMES
AmpC β-lactamases are a class of enzymes produced by certain bacteria that confer resistance to […]
Methicillin-resistant Staphylococcus aureus (MRSA): A Global Health Threat
Methicillin-resistant Staphylococcus aureus (MRSA) is a type of bacterium that has become resistant to many […]
SEMINAL FLUID (SEMEN) MICROSCOPY, CULTURE & SPERM CELL COUNT
SEMEN MICROSCOPY AIM: To determine any abnormality in a seminal fluid (semen) as an aid […]
Microbial Fermentation: Processes, Pathways, and Applications
Fermentation is a metabolic process that enables cells to extract energy from organic molecules in […]